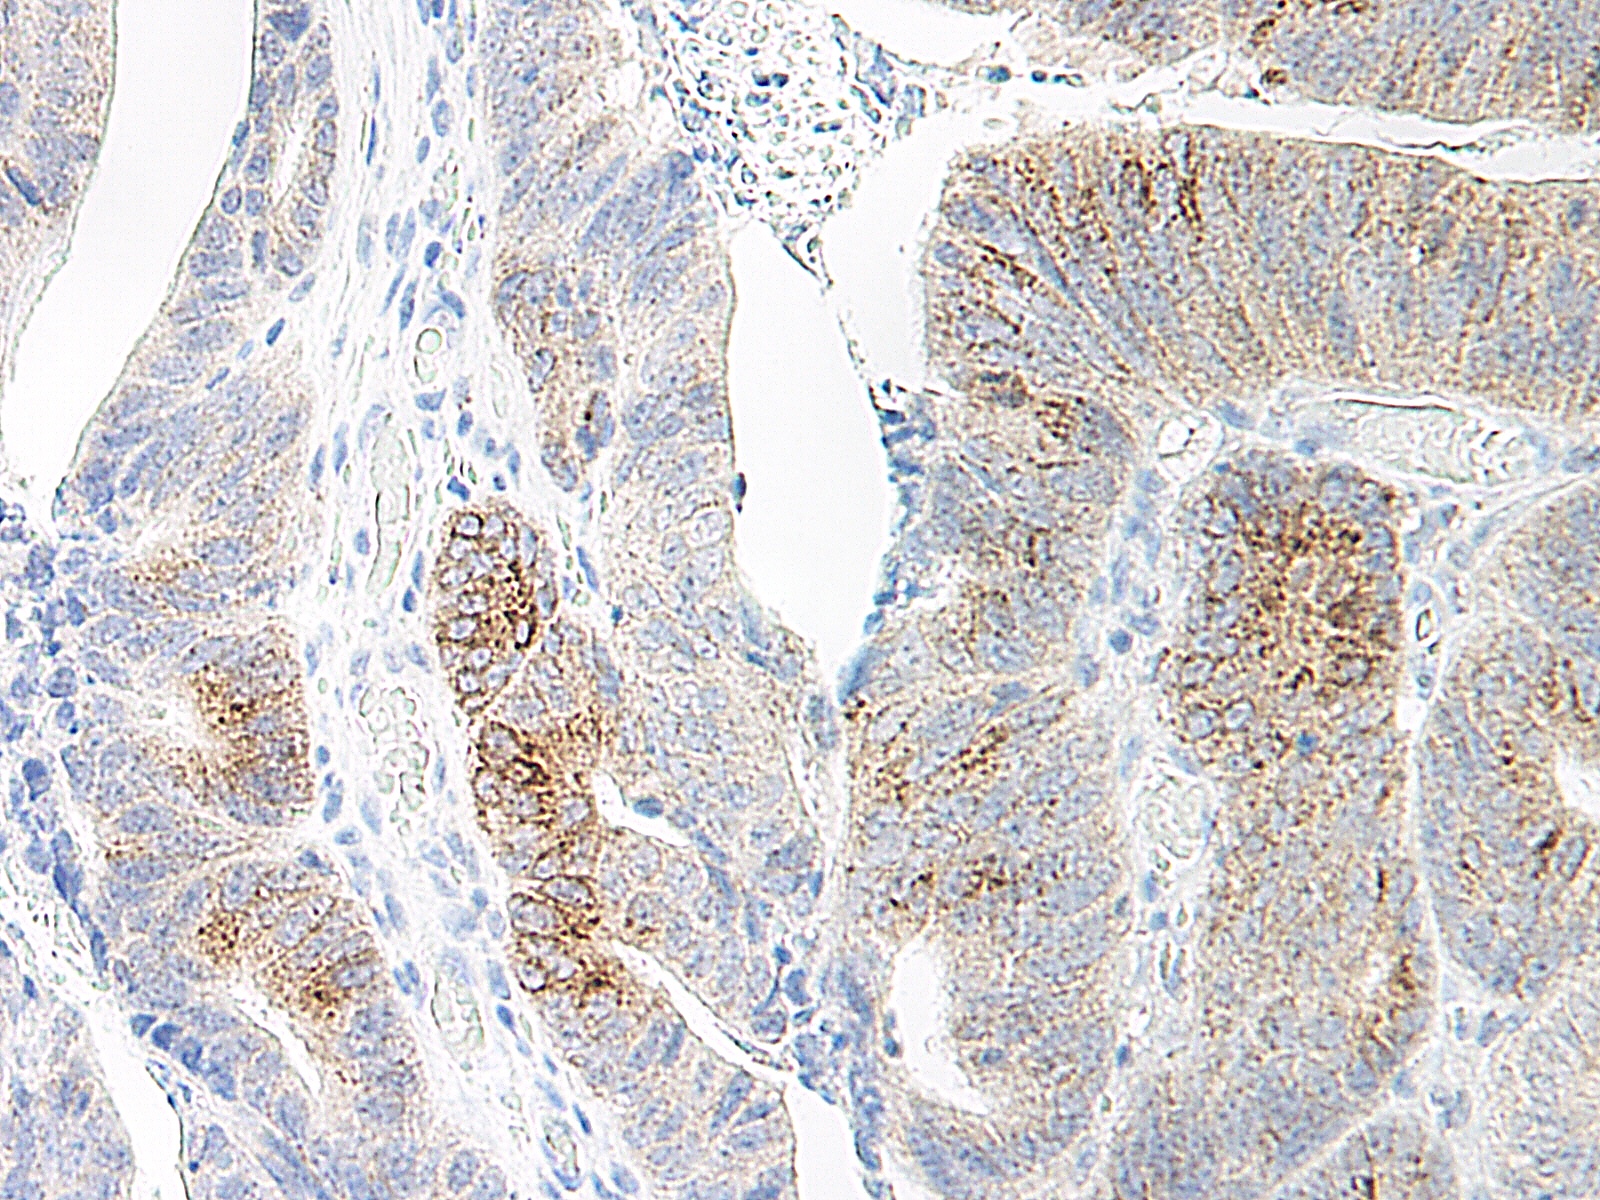
CCL20 Antibody

You have no items in your shopping cart.
MIP-3 alpha Antibody
Description
Images & Validation
−| Tested Applications | WB |
|---|---|
| Dilution Range | WB: 0.5µg/mL |
| Reactivity | Human |
| Application Notes |
Key Properties
−| Antibody Type | Primary Antibody |
|---|---|
| Host | Mouse |
| Clonality | Monoclonal |
| Isotype | IgG1 |
| Clone No. | 3N2D9 |
| Immunogen | Anti-MIP-3α (MOUSE) Monoclonal Antibody was produced in mouse by repeated immunizations with mature full length recombinant human MIP-3α produced in E.coli followed by hybridoma development. |
| Purity | Anti-MIP-3α was purified from clarified mouse ascetic fluid by Protein A chromatography followed by extensive dialysis against the buffer stated above. This antibody is specific for human MIP-3α protein. A BLAST analysis was used to suggest cross-reactivity with MIP-3α from human sources based on 100% homology with the immunizing sequence. Cross-reactivity with MIP-3α from other sources has not been determined. |
| Conjugation | Unconjugated |
Storage & Handling
−| Storage | Store vial at -20° C prior to opening. Aliquot contents and freeze at -20° C or below for extended storage. Avoid cycles of freezing and thawing. Centrifuge product if not completely clear after standing at room temperature. This product is stable for several weeks at 4° C as an undiluted liquid. Dilute only prior to immediate use. |
|---|---|
| Form/Appearance | Liquid (sterile filtered) |
| Buffer/Preservatives | Preservative: 0.01% (w/v) Sodium Azide. Stabilizer: None; Buffer: 0.02 M Potassium Phosphate, 0.15 M Sodium Chloride, pH 7.2 |
| Concentration | 1.0 mg/mL |
| Expiration Date | 12 months from date of receipt. |
| Dry Ice Shipping | Please note: This product requires shipment on dry ice. A dry ice surcharge will apply. |
| Disclaimer | For research use only |
Alternative Names
−Similar Products
−CCL20 Rabbit Polyclonal Antibody [orb10264]
IF, IHC-Fr, IHC-P
Mouse, Rat
Human
Rabbit
Polyclonal
Unconjugated
50 μl, 100 μl, 200 μl

Quality Guarantee
Explore bioreagents carefree to elevate your research. All our products are rigorously tested for performance. If a product does not perform as described on its datasheet, our scientific support team will provide expert troubleshooting, a prompt replacement, or a refund. For full details, please see our Terms & Conditions and Buying Guide. Contact us at support@biorbyt.com.

Western Blot of Human MIP 3α (Mouse) Antibody. Lane 1: human recombinant MIP-3a. Lane 2: mouse recombinant MIP-3a. Primary antibody: Human MIP 3α antibody at 0.5 ug/ml for overnight at 4°C. Secondary antibody: IRDye800™ goat anti-mouse at 1:10000 for 45 min at RT. Block: 5% BLOTTO overnight at 4°C.
Documents Download
Request a Document
MIP-3 alpha Antibody (orb345108)
Participating in our Biorbyt product reviews program enables you to support fellow scientists by sharing your firsthand experience with our products.
Login to Submit a Review